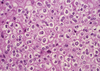

17. Central Nervous System Pathology Flashcards
(83 cards)
Leptomeninges
Pia and arachnoid mater (“light” meninges)
What is the difference in location of CNS tumors in adults vs. children?
Adults: supratentorial
Children: below the tentorium

What does the neural tube develop into?
The neural tube becomes the CNS. Purves p. 478

What is anencephaly?
Absence of skull & brain (disruption of rostral end of neural tube).
Frog-like appearance of fetus.
Maternal polyhydramnios (high amniotic fluid) because fetal swallowing is impaired.
Amyotrophic Lateral Sclerosis (ALS)
- Degeneration of upper **and **lower motor neurons of corticospinal tract
- (corticospinal tract is the upper motor neuron from cortex, crossing in medulla, down to anterior horn)
- Upper and lower motor neuron signs
- Atrophy and weakness of hands is early sign
- NO sensory impairment (distinguishes it from syringomyelia where the ant. white commissure is damaged)
- Sporadic, middle-aged adults usually
- Zinc-copper superoxide dismutase mutation (SOD1) in some familial cases –> free radical injury in neurons
What is are the important alleles of apolipoprotein E (APOE)?
What disease is it associated with?
Why?
- epsilon 4 allele - higher risk of AD (extra deposition of Abeta)
- epsilon 2 allele - lower risk of AD
- “2 lower than 4”
How can neural tube defects be detected?
Elevated AFP (alpha-fetoprotein) in amniotic fluid and maternal blood.
What are major etiologies of global cerebral ischemia?
- Low perfusion (ex: a major artery to the brain has atherosclerosis)
- Acute decrease in blood flow (ex: cardiogenic shock–heart not pumping enough blood)
- Chronic hypoxia (ex: anemia)
- Repeated hypoglycemic episodes
What is the most common cause of a subarachnoid hemorrhage?
Where is it most likely to occur?
What are some associations?
Rupture of berry aneurysm. (*lacks a media layer –> weak wall –> sacular outpouching)
Other causes: AV malformations, anticoagulated state
Most frequently in anterior circle of Willis at branch points of the ACA.
Associated w/Marfan and autosomal dominant polycystic kidney disease (ADPKD).
What is beta amyloid? (“Abeta”)
Protein that results from APP (amyloid precursor protein)
Primary component of amyloid plaques found in Alzheimer’s Disease
What do neural crest cells develop into?
Neural crest cells migrate away from the neural tube. They give rise to neurons & glia of sensory and visceral motor (autonomic) ganglia, neurosecretory cells of the adrenal gland, and neurons of the enteric nervous system. They also contibute to pigment cells, cartilage, and bone (esp. of face & skull).

Friedreich Ataxia
- Degeneration of cerebellum and spinal cord
- ataxia
- multiple spinal cord tracts damaged –> loss of proprioception, vibration sense; muscle weakness; loss of deep tendon reflexes
- autosomal recessive, expansion of GAA repeat in frataxin gene
- Frataxin is for mitochondrial ion regulation; loss results in ion buildup w/free radical damage
- presents in childhood, wheelchair bound in a fwe years
- associated w/hypertrophic cardiomyopathy
Fungi is a common cause of meningitis in what group of individuals?
Immunocompromised
Werdnig-Hoffman Disease
- Inherited degeneration of anterior motor horn
- Autosomal recessive
- Looks like polio because the same thing is being damaged
- “Flobby baby”
- Death w/in few years after birth
Spina bifida occulta
Vertebral arches don’t close, but there is no herniation of the intraspinal contents.
See a tuft of hair w/out any visible herniated contents.
What is a TIA?
Transient ischemic attack - when you have regional ischemia to the brain that lasts less than 24 hours. (Longer than 24 hours is an “ischemic stroke”).
When are folate levels important for preventing neural tube defects?
Prior to conception.
Meningomyelocele
Myelo = neurons/cord
Failure of vertebral arch to close and herniation of meninges + spinal cord.
See herniated lumbosacral sac and may see paralysis, loss of deep tendon reflexes, loss of sensation, incontinence.
Associated with type II Arnold-Chiari syndrome.
Arnold-Chiari Malformation
- Congenital downward displacement of cerebellar vermis and tonsils through foramen magnum.
- Type 1 less severe
- Type 2 more severe
- Obstruction of CSF flow –> hydrocephalus
- Meningomyelocele common
- Syringomyelia common
Common cause of meningitis in adults and elderly
- Streptococcus pneumoniae
Lumbar puncture: what level should you do it at? What layers do you go through?
- LP at L4 & L5 (iliac crest) - because cord ends at L2 but subarachnoid space goes to S2.
- Layers: skin, ligaments, epidural space, dura, and arachnoid *but don’t pierce pia!
What is the progression after an ischemic stroke?
(Focus on 1 day, 1 week, 1 month)
- 12-24 hours: Red neurons (picture)
- 24 hours: necrosis
- Neutrophils
- Microglia (macrophages of CNS)
- 1 month: Cyst surrounded by gliosis (reactive astrocytes line space w/gliotic connective tissue)

In what direction does the neural tube close?
The neural tube closes first in the middle then rostral –> caudal (head to tail). So the lower part is last to close. What would result if the rostral part didn’t close? Anencephaly. What would result if the caudal part didn’t close? Spina bifida.
What is damaged in poliomyelitis?
What symtoms result?
- Anterior horn cells are damaged
- Lower motor neuron signs:
- flaccid paralysis with muscle atrophy
- fasciculations
- weakness with decreased tone
- impaired reflexes
- negative Babinski (downgoing toes)